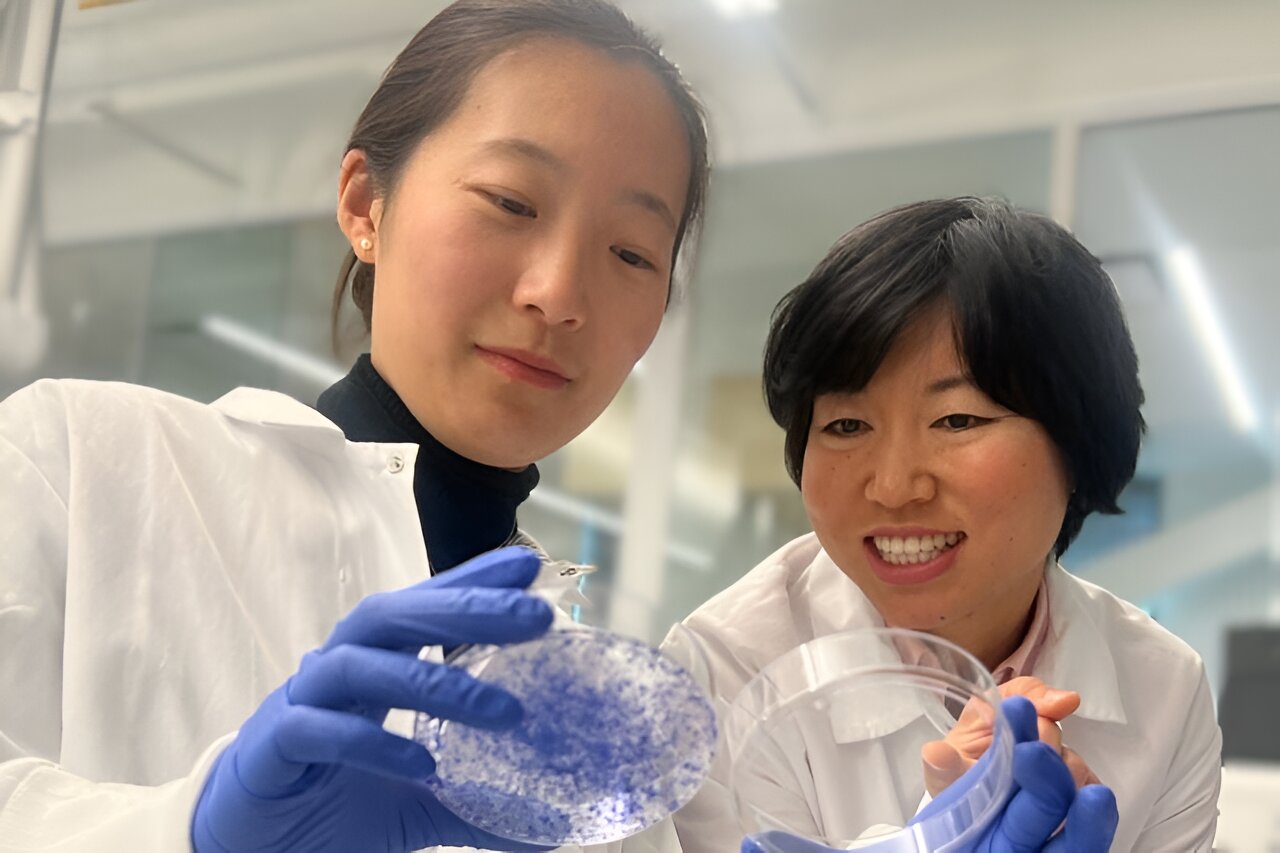
Featured image for "Breakthrough Discovery: Controlling Breast Cancer Metastasis with an On/Off Switch"

Selective 'mirror' amino acid inhibits specific tumor growth
Researchers have discovered that D-cysteine, a mirror form of the amino acid cysteine, selectively inhibits the growth of certain cancer cells by blocking a key mitochondrial enzyme, showing promise for targeted cancer therapies with minimal effects on healthy cells, as demonstrated in mouse models.